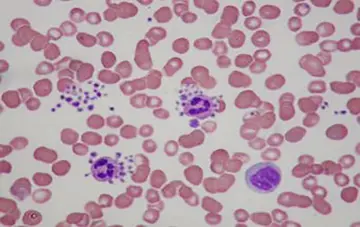

1
سندروم واردنبرگ (WAARDENBURG SYNDROME) یک بیماری ژنتیکی نادر است که روی رنگ پوست ، مو و چشم را تحت تأثیر قرار میدهد. سندروم واردنبرگ همچنین می تواند سبب از دست دادن کامل یا افت شنوایی گردد . چهار نوع اصلی از سندروم واردنبرگ وجود دارد که از نظر ویژگیهای ظاهری خود متمایز می شوند.